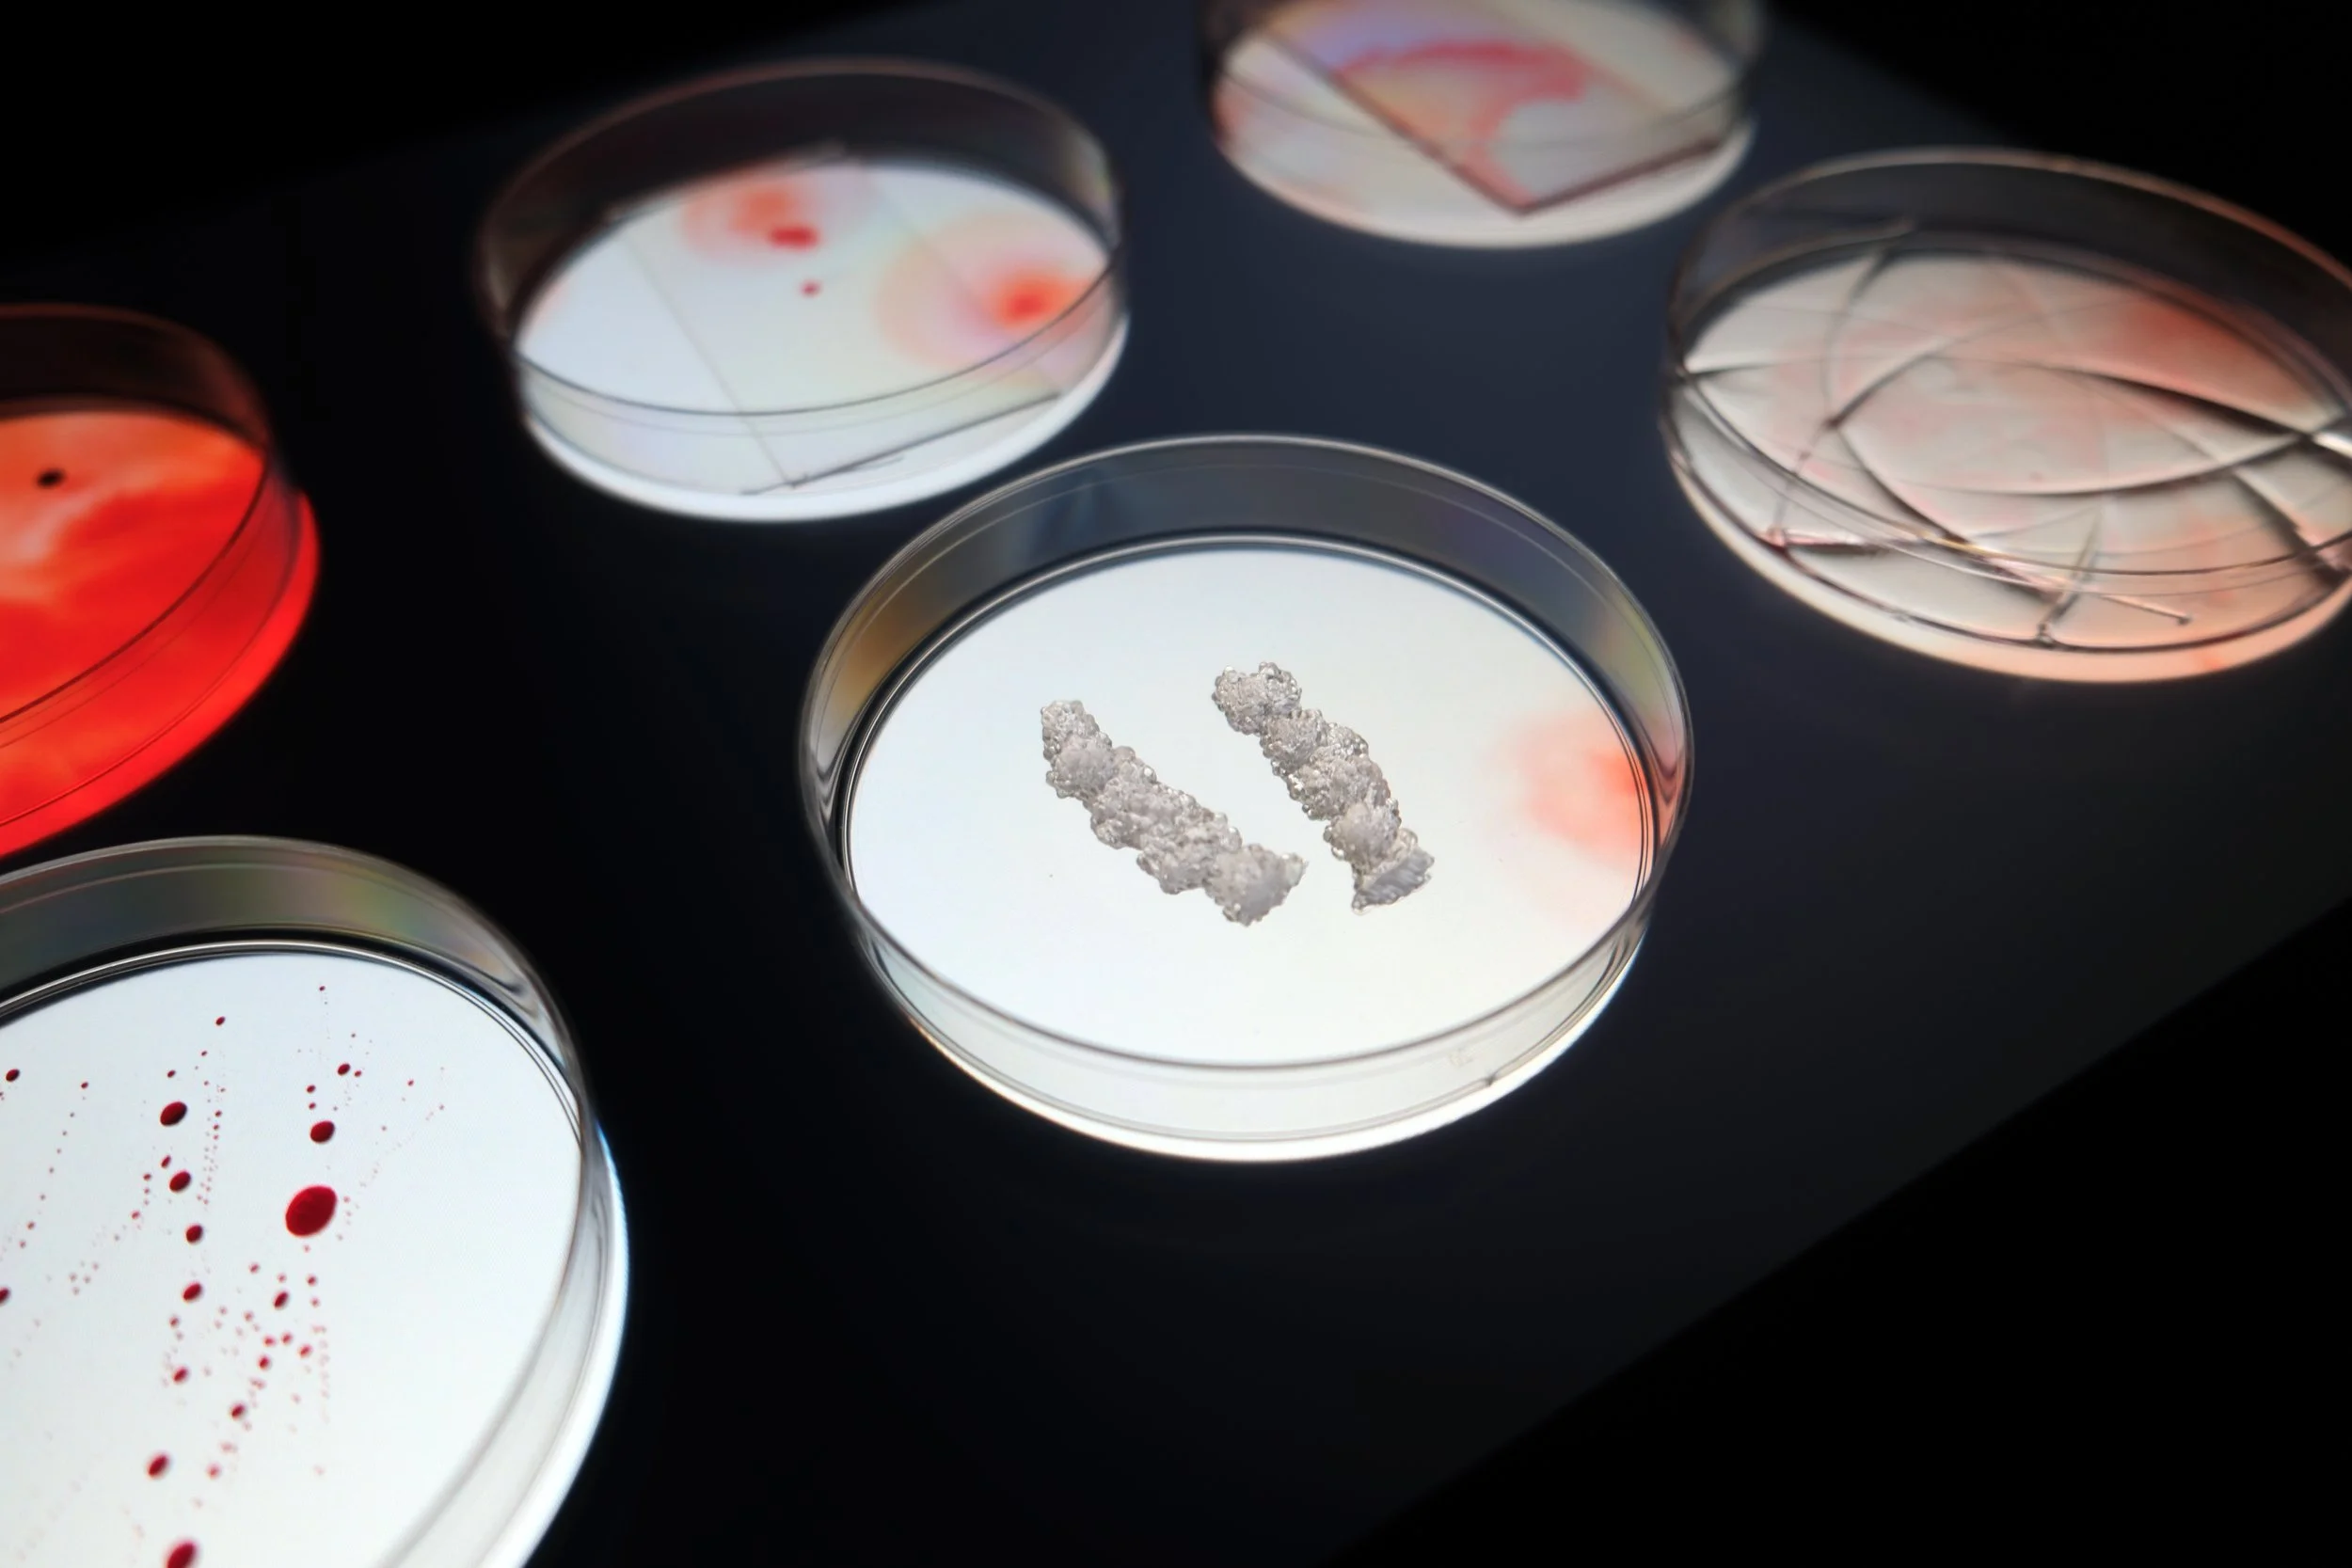
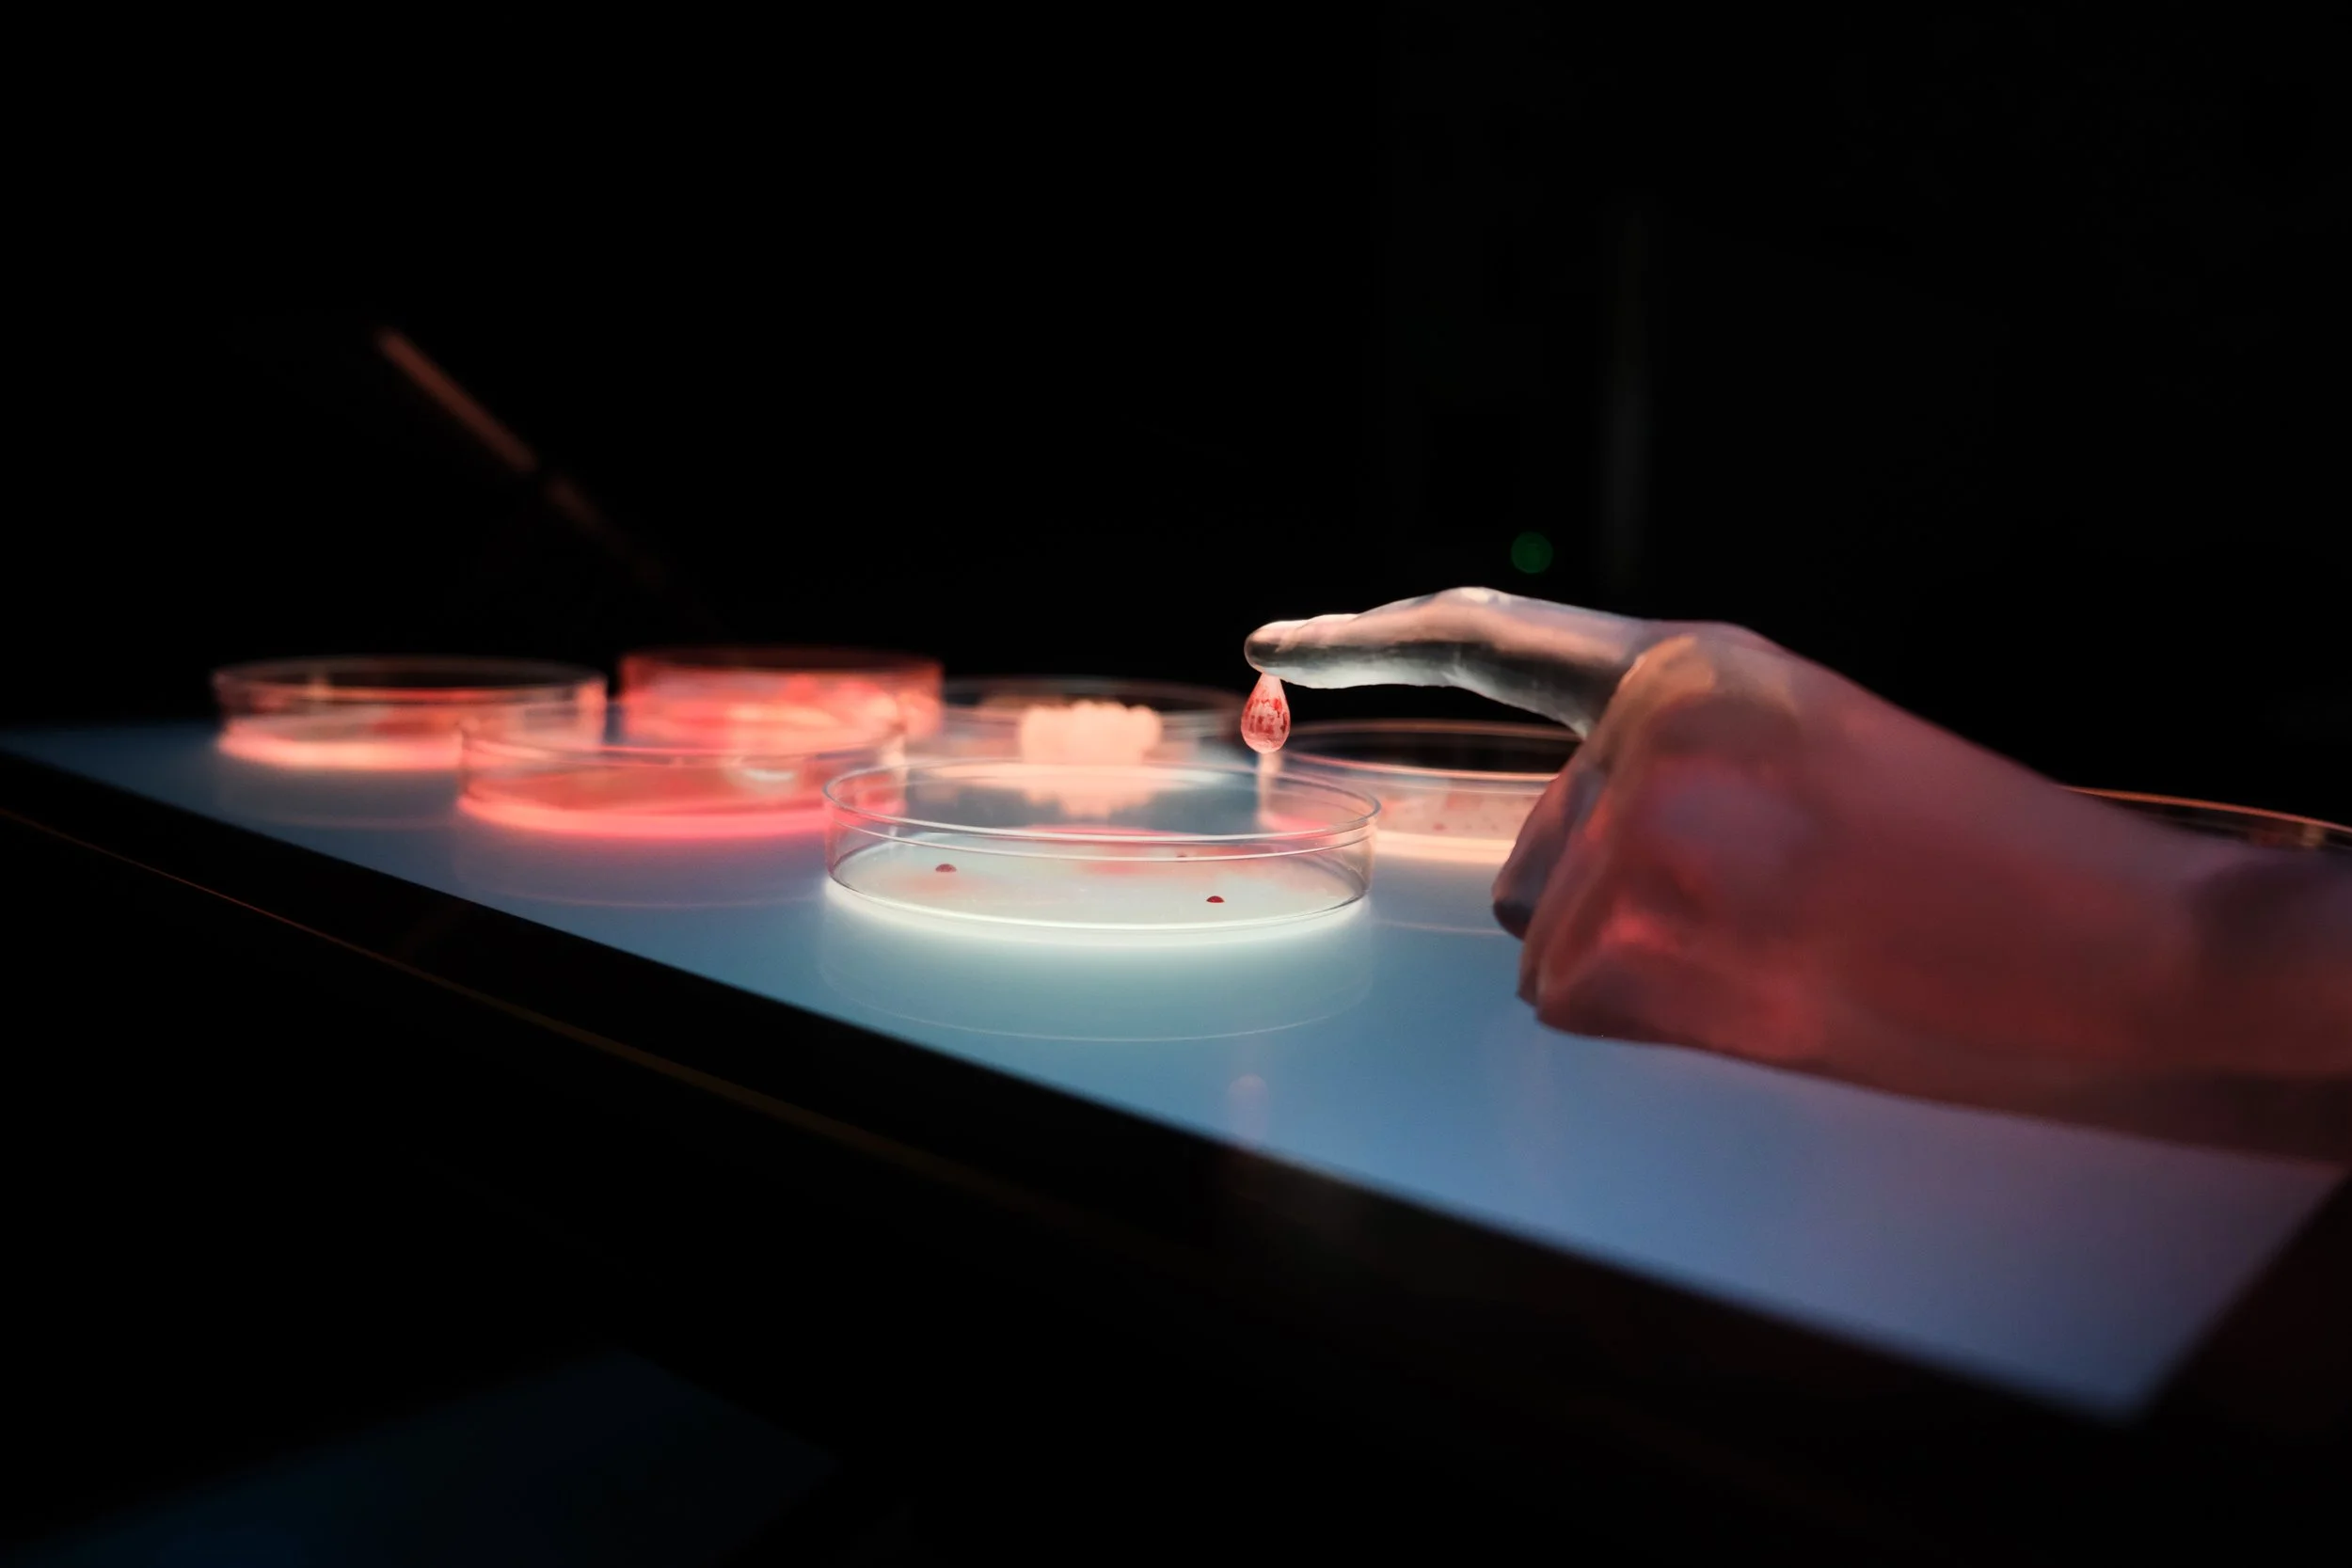

Nanoscopia 1.0
Index Of Being
2025
Index of Being is a dynamic art installation and sculpture that explores the intersection of human identity, biology, and cutting-edge diagnostic technology. The work simulates the scientific process of nanowire biosensor development for DNA detection, originating from a drop of blood sampled from a fingertip. It aims to evoke contemplation on the nature of self as revealed through technological mediation and the aesthetics of otherwise invisible biological and scientific processes.
Read More